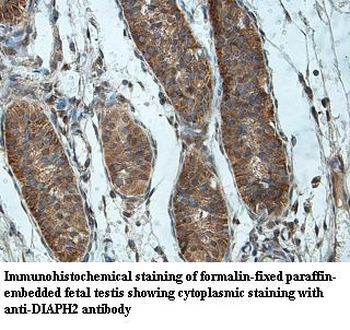
DIAPH2 Rabbit Polyclonal Antibody

You have no items in your shopping cart.
Search results for: 'DIAPH2'
- Featured
Featured
IF, IHC-Fr, IHC-P
Rat
Canine, Equine, Human, Rabbit
Rabbit
Polyclonal
Unconjugated
50 μl, 100 μl, 200 μl - Featured

ELISA, IHC, WB
Human
Mouse, Rat
Rabbit
Polyclonal
Unconjugated
100 μg125.4 kDa
Human
20 μg- Featured
Featured
WB
Human, Mouse, Rat
Rabbit
Polyclonal
Unconjugated
200 μl, 100 μl, 30 μl, 50 μl WB
Human
Human
Rabbit
Polyclonal
Unconjugated
100 μlWB
Rat
Bovine, Canine, Equine, Guinea pig, Human, Mouse, Porcine, Rabbit, Yeast, Zebrafish
Rabbit
Polyclonal
Unconjugated
100 μl125.4 kDa
Human
100 μg